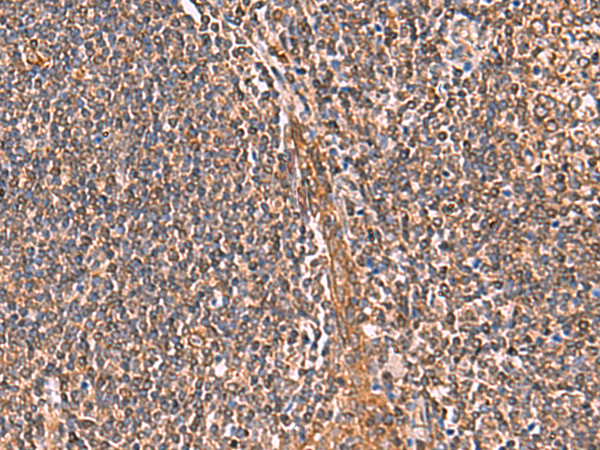

-
分类: 科研抗体货号: P06729别名: INA5; INFA5; leIF G; IFN-alphaG; IFN-alpha-5应用: WB反应种属: Human
-
分类: 科研抗体货号: P06776别名: syd; JIP3; SYD2; JIP-3; JSAP1应用: IHC反应种属: Human
-
分类: 科研抗体货号: P06800别名: KT3.3; TASK5; KCNK11; KCNK14; TASK-5; K2p15.1; dJ781B1.1应用: WB,IHC反应种属: Human
-
分类: 科研抗体货号: P06775别名: JUNDM2应用: IHC反应种属: Human, Mouse, Rat
-
分类: 科研抗体货号: P06794别名: KLHDC7C应用: WB反应种属: Human, Mouse
-
分类: 科研抗体货号: P06768别名: OLC1应用: WB,IHC反应种属: Human, Mouse, Rat
-
分类: 科研抗体货号: P06792别名: ANOP3; MCOPS3应用: WB,IHC反应种属: Human, Mouse
-
分类: 科研抗体货号: P06767别名: ISM; Isthmin; C20orf82; bA149I18.1; dJ1077I2.1应用: WB,IHC反应种属: Human, Mouse
-
分类: 科研抗体货号: P06789别名:应用: WB,IHC反应种属: Human, Mouse
-
分类: 科研抗体货号: P06845别名: HH8; CPPB1; GPR54; AXOR12; KISS-1R; HOT7T175应用: WB反应种属: Human

鄂公网安备42018502007531号
鄂公网安备42018502007531号

